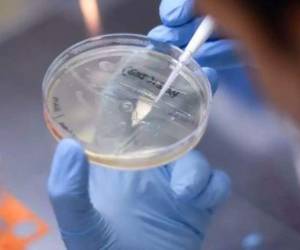
Hasta este lunes, Chile contabilizaba un total de 20,647 casos de covid-19 activos. FOTO: AFP

SANTIAGO, CHILE.- Seis adultos mayores fallecieron y
ocho personas más resultados lesionadas en un incendio en una casa de acogida de pacientes dados de alta de un
hospital psiquiátrico en Chile, informaron el viernes las autoridades.
El siniestro se registró la noche del jueves en San Felipe, 90 kilómetros al noroeste de Santiago, y también provocó daños en cuatro viviendas aledañas, señalaron los bomberos y la Oficina de Emergencia del Ministerio del Interior ( ONEMI).
VEA: Japón extiende la emergencia sanitaria por el covid tras una semana del inicio de los Juegos
Peritos del Servicio Médico Legal trabajaban en identificar a los fallecidos debido al estado en que quedaron.
El comandante de bomberos de San Felipe, Juan Carlos Herrera, dijo a la prensa que al llegar al lugar el fuego ya se propagaba al interior del hogar.
DE INTERÉS: Nueva York paga 100 dólares a personas que se apliquen la vacuna contra el coronavirus
Entre las posibles causas del incendio se barajan un recalentamiento de una estufa a gas o un recalentamiento del sistema eléctrico.
ADEMÁS: La variante delta del covid-19 obliga a endurecer las restricciones en el mundo
El incendio destruyó completamente la casa de acogida, que es administrada por el gobierno.
El siniestro se registró la noche del jueves en San Felipe, 90 kilómetros al noroeste de Santiago, y también provocó daños en cuatro viviendas aledañas, señalaron los bomberos y la Oficina de Emergencia del Ministerio del Interior ( ONEMI).
VEA: Japón extiende la emergencia sanitaria por el covid tras una semana del inicio de los Juegos
Peritos del Servicio Médico Legal trabajaban en identificar a los fallecidos debido al estado en que quedaron.
El comandante de bomberos de San Felipe, Juan Carlos Herrera, dijo a la prensa que al llegar al lugar el fuego ya se propagaba al interior del hogar.
DE INTERÉS: Nueva York paga 100 dólares a personas que se apliquen la vacuna contra el coronavirus
Entre las posibles causas del incendio se barajan un recalentamiento de una estufa a gas o un recalentamiento del sistema eléctrico.
ADEMÁS: La variante delta del covid-19 obliga a endurecer las restricciones en el mundo
El incendio destruyó completamente la casa de acogida, que es administrada por el gobierno.